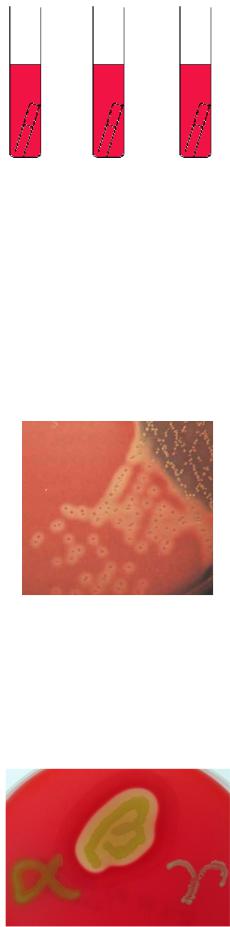

Материал: Грамположительные аэробные Кокки

36
Морфологические и тинкториальные свойства стрептококков.
Стрептококки представляют собой грамположительные клетки сферической формы размером 0,5-2,0 мкм. Неподвижные, не образуют спор. Некоторые виды стрептококков формируют капсулу. Имеют пили (фимбрии). В мазках из агаровых культур стрептококки располагаются короткими цепочками, в препаратах из бульонных культур – длинными цепочками (рисунок 52).
а б в Рисунок 52 – Компьютерная визуализация (а), окраска по Граму (б) и электронная
фотография (в) стрептококков.
Клеточная стенка стрептококков имеет наружный белковый слой (содержит Т- и М-белки), средний полисахаридный слой (состоит из N-ацетилглюкозамина и L-рамнозы) и внутренний слой (представлен пептидогликаном). Из клеточной стенки через гиалуроновую капсулу выступают фимбрии, содержащие М-белок и липотейхоевую кислоту.
Культуральные и биохимические свойства стрептококков. Стрептококки являются факультативными анаэробами. Хорошо растут в аэробных условиях на питательных средах с кровью, сывороткой крови, асцитической жидкостью, глюкозой. На плотных средах образуют мелкие сероватые колонии. В жидких средах растут в виде небольшого осадка (рисунок 53).
а б Рисунок 53 – Характер роста стрептококков на кровяном агаре (а) и в жидкой
питательной среде (б).
Стрептококки ферментируют глюкозу, мальтозу, сахарозу и некоторые другие углеводы с образованием кислоты без газа (рисунок 54), протеолитическими свойствами не обладают. Каталазоотрицательные.
37
Глюкоза Мальтоза Сахароза
Рисунок 54 – Ферментация углеводов стрептококками.
По характеру роста на кровяном агаре выделяют три группы стрептококков:
--гемолитические стрептококки вызывают образование вокруг колоний зоны зеленоватого цвета, обусловленное превращением гемоглобина в метгемоглобин (условно-патогенные стрептококки, “зеленящие стрептококки” или стрептококки группы “viridans”, например, S. mutans);
--гемолитические стрептококки формируют колонии, окруженные зоной полного гемолиза (рисунок 55); к ним относятся патогенные стрептококки, основные возбудители гнойно-воспалительных заболеваний человека, например, S. pyogenes;
Рисунок 55 – Гемолиз эритроцитов β-гемолитическими стрептококками.
- -стрептококки (негемолитические стрептококки) не образуют зоны гемолиза вокруг колоний (например, S. mitis).
Проявление гемолитической активности разных видов стрептококков хорошо иллюстрирует рисунок 56.
Рисунок 56 – Характер гемолиза у разных видов стрептококков.
38
Альфа-гемолитические стрептококки широко представлены в ротовой полости, поэтому часто называются оральными стрептококками. Бетагемолитические стрептококки редко выделяются от здоровых людей, большинство из них являются болезнетворными. Негемолитические стрептококки входят в состав облигатной микробиоты человека.
Антигенная структура стрептококков. Стрептококки имеют групповой полисахаридный С-антиген, в зависимости от особенностей строения которого стрептококки разделены на серогруппы. С-антиген локализуется в клеточной стенке стрептококков. Некоторые виды стрептококков не имеют С-антигена.
В клеточной стенке стрептококков локализуется также белковый М-антиген. Он обладает типовой специфичностью. Структурно М-белок представляет филаменты (пили, фимбрии). По строению М-антигена стрептококки группы А подразделяются на серовары (более 100 сероваров).
Стрептококки имеют так называемые перекрестно реагирующие антигены. Антитела к таким антигенам взаимодействуют (перекрестно реагируют) с тканями миокарда, скелетных мышц, почек.
Резистентность стрептококков. Во внешней среде стрептококки сохраняются в течение нескольких дней. Они выдерживают нагревание до 50-70 С в течение 30 минут, хорошо переносят низкие температуры. Стрептококки продолжительное время сохраняются на предметах, окружающих больного, в пыли. В гное, мокроте стрептококки сохраняются месяцами. Чувствительны к дезинфицирующим веществам: например, в 3% феноле они погибают через 15 минут.
Стрептококки чувствительны к пенициллину, устойчивость к пенициллину у них возникает очень редко. К другим же антибиотикам и сульфаниламидам у стрептококков часто развивается резистентность.
Факторы патогенности стрептококков. Основные факторы патогенности стрептококков представлены в таблице 4 и на рисунке 57. Наличие тех или иных факторов патогенности и их соотношение определяет различную вирулентность штаммов стрептококков. Наибольшей патогенностью для человека обладают бетагемолитические стрептококки серологической группы А.
Таблица 4 – Факторы патогенности стрептококков
Факторы |
Роль в развитии инфекции |
1. Структурные компоненты клетки |
|
М-протеин и М-подобные |
Предотвращают активацию комплемента по |
поверхностные протеины (T-, |
альтернативному пути и препятствуют |
R-белки) |
фагоцитозу; медиаторы адгезии к кератиноцитам |
|
кожи |
Капсула |
Защита от фагоцитоза, фактор адгезии и тканевой |
|
инвазии |
Фибронектин связывающие |
Обеспечивают адгезию, связывают фибронектин, |
белки (протеины F1, F2, Sfb1, |
способствуют формированию обширных |
Sfb2, SOF, PFBP, FbaA, FbaB) |
бактериальных агрегатов и обеспечивают защиту |
|
от фагоцитоза в присутствии опсонизирующих |

|
39 |
|
антител |
Липотейхоевая кислота (LTA) |
Адгезия к клеткам эпителия |
2. Секретируемые факторы |
|
2.1. Ферменты агрессии |
|
Стрептокиназа (фибринолизин) |
Фибринолитическая активность, распространение |
|
стрептококков в тканях |
Гиалуронидаза |
Фактор инвазии |
Пептидаза |
Способствует распространению бактерий в тканях |
ДНКаза (стрептодорназа) |
Фактор инвазии |
IgG-разрушающий фермент |
Защищает бактерии от опсонизирующих антител, |
|
ингибирует фагоцитоз |
2.2. Токсины |
|
Стрептолизины О и S |
Порообразующие цитотоксины |
(гемолизины) |
|
Стрептококковые пирогенные |
Некротическое действие на эндотелий сосудов |
экзотоксины (streptococcal |
|
pyrogenic exotoxins, SPE) типов |
|
А, В и С |
|
Лейкоцидин |
Разрушение лейкоцитов |
3. Медиаторы межмикробного взаимодействия |
|
Стрептоцины (бактериоцины) |
Участие в заселении определенных биотопов |
|
Капсула |
|
Клеточная стенка |
|
Цитоплазматическая мембрана |
Sfb |
М-протеин |
|
|
Токсины |
F-протеин |
|
|
|
LTA |
Экзоферменты
Рисунок 57 – Факторы патогенности стрептококков.
Белок М (mucoid - слизистый) является одним из основных факторов патогенности стрептококков группы А. По структуре он напоминает пили (ворсинки), определяет адгезивные свойства, угнетает фагоцитоз, адсорбирует на своей поверхности фибриноген и фибрин, маскируя рецепторы для комплемента и опсонинов. Молекула М-белка состоит из двух цепей, образующих спираль. М-

40
белок включает в себя консервативный и гипервариабельный участки. Консервативный участок связывает фибриноген и Fc-фрагменты IgG, формируя псевдокапсулу на поверхности стрептококка. Гипервариабельный участок отвечает за разнообразие эпитопов: известно более 100 вариантов белка, характерных определенному серотипу. Эти варианты отличаются друг от друга последовательностью аминокислот в дистальной (N-концевой) части молекулы (рисунок 58).
Гипервариабельный
участок
|
М-протеин |
Консервативный |
OMP |
участок
Наружная
мембрана
 MFP
MFP 
 Пептидогликан
Пептидогликан
Цитоплазматическая
ЦПМ
мембрана
ABC
Рисунок 58 – Структура М-белка S. pyogenes.
Т-белки у большинства стрептококков представлены в виде стабильных комплексов, включающих 2-3 белка. Среди них один белок является основным, а два – вспомогательными. Основной белок определяет Т-тип стрептококка. По Т- белку стрептококки группы А также подразделяются на серовары (несколько десятков).
R-белок обнаруживается у стрептококков серогрупп В, С и D. Он чувствителен к пепсину, разрушается при высокой температуре. Его роль в развитии инфекций окончательно не ясна.
Капсула у стрептококков групп А и С образована гиалуроновой кислотой, а у S. pneumoniae – полисахаридом. Капсула облегчает адгезию микробных клеток к эпителию, препятствует фагоцитозу, экранирует пептидогликан. Гиалуроновая кислота капсулы S. pyogenes аналогична гиалуроновой кислоте млекопитающих, поэтому затрудняет формирование эффективного иммунного ответа на возбудителя инфекции. Кроме собственной капсулы стрептококк способен фиксировать на своей поверхности белки макроорганизма (фибриноген, плазминоген, фибронектин, коллаген и др.), создавая капсулоподобную структуру, защищающую микробную клетку от повреждающих факторов макроорганизма.
Фибронектин-связывающие белки (F1, F2, Sfb1, Sfb2, SOF, PFBP, FbaA, FbaB) способствуют формированию агрегатов и защищают микробные клетки от фагоцитоза. Каждый из этих белков присущ определенному М-типу стрептококка.